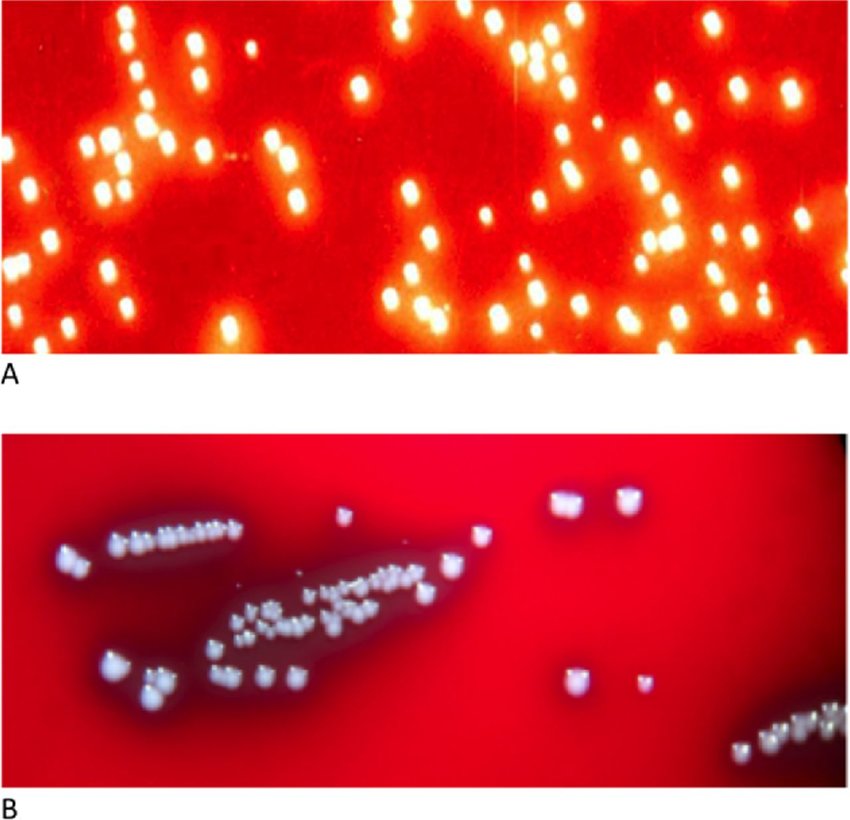
Bordetella pertussis (A) and B. parapertussis (B) grown on Bordet and Gengos medium. - Bordetella pertussis(A) andB. parapertussis(B) grown on Bordet and Gengos medium. (Image source: Ref-5)

Bordetella pertussis is a small Gram-negative coccobacillus. It is the causative agent of whooping cough (pertussis), an acute respiratory infection most common in children. Two species, B. pertussis and B. parapertussis cause pertussis in humans. Other members such as B. bronchiseptica, B avium , B hinziicause respiratory disease in various animals and poultry and are very rarely found in humans.
Bordetella pertussiswas first isolated in pure culture in 1906 by two scientists Bordet and Gengou.
General characteristics

- Bordetella pertussis is a small rod-shaped, coccoid, or ovoid Gram-negative bacterium.
- It is encapsulated and does not producespores.
- It is a strict aerobe.
- It is arranged singly or in small groups.
- B pertussis and B parapertussis are nonmotile.
- The bacteria are nutritionally fastidious and are usually cultivated on rich media supplemented with blood.
Virulence factors
Bordetella pertussis produces a number of virulence factors, including pertussis toxin, adenylate cyclase toxin, adhesins, and hemolysin.
- Pertussis toxin (PT): Pertussis toxin is a protein exotoxin, secreted during in vivo and in vitro growth and consists of five different subunits, designated S1, S2, S3, S4, and S5. The toxin reacts with different cell types, including T lymphocytes, and acts on different cellular regulatory processes
- Adenylate cyclase toxin: It is a protein toxin that penetrates the host cell, and when activated by host cell calmodulin, increases intracellular CAMP massively. The increase of CAMP, is associated with the inhibition of phagocytic cell oxidative responses and natural killer cell (NK) activity.
- Adhesins: Filamentous hemagglutinin (FHA), pertactin (PRN), and fimbriae (FIM) are adhesion proteins that have been used as antigens. Filamentous hemagglutinin also causes agglutination of RBC.
Pathogenesis and clinical manifestations
Source and transmission: Humans are the only host for B.pertussis. The bacterium resides in the upper airways, mostly the trachea and the bronchi. It is transmitted from person to person through droplets of respiratory secretions that are either coughed or sneezed into the air by an infected person.
The clinical manifestation consists of 3 stages.
- Catarrhal phase: After an incubation period of 1 to 2 weeks, whooping cough begins with the catarrhal phase. This phase lasts 1 to 2 weeks and is usually characterized by low-grade fever, rhinorrhea, and progressive cough; the patient is highly infectious.
- Paroxysmal phase: The subsequent paroxysmal phase, lasting 2 to 4 weeks, is characterized by severe and spasmodic cough paroxysms (i.e. a series of cough followed by a rapid inhalation of air âa whoopâ). In this phase, patients may exhibit leukemoid reaction (⼠100,000/mm3), with 60 to 80 percent being lymphocytes. The patient is considered non-infectious after 6 weeks even if the coughing persists.
- **Convalescent phase:**This phase lasts about 1 to 3 weeks and is characterized by a decrease in frequency and severity of coughing, but secondary serious complications such as bronchopneumonia and acute encephalopathy may occur resulting in death.
Laboratory diagnosis
Sample: AÂ nasopharyngeal swab or exudate. Dacron or calcium alginate swabs are preferred and inoculated immediately on a culture medium. If immediate inoculation is not possible, a sample should be placed in Reagan Lowe (RL) or Amies medium containing charcoal transport medium.
| Character | B.pertussis | B.parapertussis |
|---|---|---|
| Colony on bordet gangou medium | Small (about 1mm after 3 days incubation) glistening like mercury droplets and non-hemolytic. | Appear greyish and non-hemolytic |
| Growth rate | Slow grower | Grows faster as compared to B. pertussis |
| Growth on blood free peptone agar | Absent | Present |
| Pigment formation on tyrosine agar | Non pigmented | Produce brown pigment |
| Urease activity | Negative | Positive |
| Oxidase reaction | Positive | Negative |
If culture cannot be performed immediately, it is possible to keep the biological samples at -80 °C and perform the culture later on.
Microscopy: On Gram staining,Bordetella pertussis appears as small Gram-negative coccobacilliarranged singly or in small groups.
Rapid diagnosis of pertussis can also be made by examining smears of nasopharyngeal secretions using fluorescein-labeled antibodies to B.pertussis. The organism appears as an apple green fluorescent coccobacilli.
Culture:
Culture is the gold standard method for the diagnosis of pertussis. The specimens should be plated immediately onto selective media, such as Regan-Lowe agar or freshly prepared Bordet-Gengou agar or BYCE plate with added cephalosporin for selective growth.
Colonies of B. pertussis appear small, shiny, mercury drop-like after 3-5 days incubation at 37°C.
Suspected colonies are further identified and differentiated based on the growth rate, colony morphology, various biochemical reactions, and slide agglutination with antisera.
Serological tests: Since, the rate of isolation of Bordetella is very low in suspected individuals especially after the catarrhal stage, serological tests based on agglutination, complement fixation, and immunofluorescence are widely used.
In the absence of recent immunization, an elevated serum IgG antibody to PT after 2 weeks of cough onset is suggestive of recent B. pertussisinfection.
Enzyme immunoassay (EIA) for detection of IgM, IgA, and IgG antibodies to B. pertussisand is particularly useful in diagnosis during the late stage of the disease when other tests are negative.
**PCR:**Results are available 1-2 days. Several polymerase chain reaction (PCR) assays have been developed for the rapid diagnosis of B. pertussisinfection. Usually, two types of samples, nasopharyngeal aspirates or nasopharyngeal swabs (taken as for cultures) have been used. When effective antimicrobial therapy is started several days before the specimen is collected, the patient is likely to be PCR positive but culture-negative. Â
In immunized persons the laboratory confirmation of the diagnosis of pertussis is difficult, and combinations of culture, PCR, and EIA serology should be used. Epidemiological data and laboratory-confirmed contact patients often help in the diagnosis.
Serotyping of *Bordetella pertussis:*Serotyping i.e. the detection of the expression of the fimbriae Fim 2 and Fim 3, is performed using monoclonal antibodies.
Treatment and immunization
Immunity to pertussis, acquired either from natural infection or through vaccination, is not lifelong. Vaccination of susceptible persons is the most important preventive strategy against pertussis. There are two types:  the whole-cell vaccine (wP), and the acellular vaccine (aP). Vaccination against pertussis is given in combination with other agents in two forms:
- Diphtheria, tetanus, and pertussis (DTaP) vaccines: Babies and children younger than 7 years old receive DTaP
- Tetanus, diphtheria, and pertussis (Tdap) vaccines: preteens, teens and adults receive Tdap.
The macrolide agents erythromycin, clarithromycin, and azithromycin are preferred for the treatment of pertussis, however, the choice depends on many other factors, such as age, the severity of disease, underlying conditions etc.
References and further readings
- Finger H, von Koenig CHW. Bordetella. In: Baron S, editor. Medical Microbiology. 4th edition. Galveston (TX): University of Texas Medical Branch at Galveston; 1996. Chapter 31. Available from: https://www.ncbi.nlm.nih.gov/books/NBK7813/
- Kenneth Todar. âBordetella pertussisâ. Todarâs Online Textbook of Bacteriology. âThe Good, the Bad, and the Deadlyâ.
- Laboratory Manual for the diagnosis of Whooping Cough caused by Bordetella pertussis, World Health Organization 2014.
- Manual for the Surveillance of Vaccine-Preventable Diseases, chapter 10, CDC.
- Bouchez, ValĂŠrie & Guiso, Nicole. (2015). Bordetella pertussis, B. parapertussis, vaccines and cycles of whooping cough. Pathogens and disease. 73. 10.1093/femspd/ftv055.